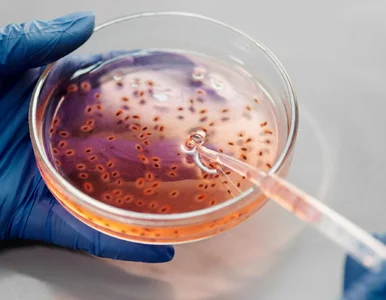
Miniatura: Odkryto nowy typ bakterii. Są zdolne do...

-
Bodnar był na UW w czasie ataku. Szczegóły mrożą krew w żyłach
Dramatyczne wydarzenia rozegrały się na terenie UW. Jak się okazuje, w czasie morderstwa na kampusie przebywał Adam Bodnar.
KrajWarszawa
-
Poruszający album Mai z Mławy. „Przepraszam cię mamo”
Ciotka Mai z Mławy pokazała greckiej dziennikarce album, który 16-latka przygotowała dla swojej matki. „Przepraszam cię mamo za błędy, ale powiedz, jak mam się zachować” – widać na jednej z kartek.
KrajŚwiat
-
Makabryczna zbrodnia na UW. Wiadomo, kim jest sprawca
Dramatyczne wydarzenia rozegrały się na terenie kampusu UW. Sprawca napaści trafił już w ręce służb. Co o nim wiadomo?
Kraj
-
„Kwiat Dojrzałości” debiutuje w USA! Polonijna edycja startuje w Chicago!
„Kwiat Dojrzałości” to ogólnopolska inicjatywa społeczna, która powstała z potrzeby docenienia kobiet dojrzałych – tych, które mimo upływu lat wciąż pozostają aktywne, zaangażowane społecznie i pełne pasji.
Festiwale/Przeglądy
-
Najlepszy sposób na mole w szafie. Zrób te kulki, a problem zniknie bez chemii
Domowe kulki na mole odzieżowe skutecznie odstraszają szkodniki dzięki naturalnym olejkom eterycznym. Dowiedz się, jak je zrobić i dlaczego naprawdę działają.
 Ewa Jagalska
Ewa Jagalska
-
Szokująca zbrodnia na kampusie UW. Nie żyje jedna osoba
Do szokującej zbrodni doszło na terenie kampusu Uniwersytetu Warszawskiego. Do akcji wkroczyły służby.
KrajWarszawa
-
Wsyp do dozownika i uruchom program. Pralka będzie jak nowa – bez kamienia, pleśni i przykrego zapachu
Czyszczenie pralki to nie fanaberia, lecz konieczność. Nie potrzebujesz drogich detergentów – wystarczy zrozumieć, jak działają składniki, które masz pod ręką.
 Ewa Jagalska
Ewa Jagalska
-
Ani raj, ani pingwiny
Głód to największy skandal dzisiejszego świata – mówi Kasia Urban, reżyserka dokumentu „Naprawdę daleko” oraz dyrektor kreatywna w Polskiej Fundacji dla Afryki.
Art. sponsorowany
-
Zaginął w tajemniczych okolicznościach. Śledczy mają nowy trop
Michał Karaś zaginął 25 lat temu. Według rodziny mógł paść ofiarą przestępstwa. Śledczy po wielu analizach materiałów dowodowych znaleźli nowy trop.
Kraj
-
Odkryto nowy typ bakterii. Są zdolne do przewodzenia prądu
Amerykańscy naukowcy odkryli nowy typ bakterii. Jej unikalne cechy mogą być przełomem w rozwoju bioelektroniki.
ŚwiatNauka
-
Legendarny polski muzyk nie żyje. Jego ciało znaleziono w samochodzie
DJ Hazel nie żyje. Legendarny polski muzyk zmarł w tajemniczych okolicznościach, których wyjaśnieniem zajmie się policja.
GwiazdyPrime time
-
Wstrząsające poglądy niemieckich uczniów. „Polacy sprowokowali II wojnę światową”
Polacy sprowokowali drugą wojnę światową? Tak uważa część niemieckich uczniów. Sprawa niepokoi nauczycieli historii.
HistoriaŚwiat
-
Przykry atak na medyka. Pijany pacjent groził ratownikowi śmiercią
Mieszkaniec Sokółki na Podlasiu groził ratownikowi medycznemu śmiercią. Jak się okazało, był pod wpływem alkoholu.
Kraj
-
Jest decyzja ZEA ws. ekstradycji Sebastiana M. Sikorski zwrócił się do Bodnara
Sąd Najwyższy Zjednoczonych Emiratów Arabskich stwierdził prawną dopuszczalność wydania Sebastiana M. Polsce. „Pirat drogowy, który zbiegł do Dubaju stanie przed polskim wymiarem sprawiedliwości” – zwrócił się Radosław Sikorski do Adama...
Kraj
-
Słaby uścisk dłoni? Twoje ciało może błagać o pomoc. Zrób prosty test
Czy masz uścisk jak śledź, czy raczej jak imadło? Siła, z jaką zaciskasz dłoń, to coś więcej niż tylko efekt ćwiczeń czy genetyki. Coraz więcej badań pokazuje, że moc chwytu może być lustrzanym odbiciem Twojego stanu zdrowia, kondycji...
Nauka
-
Syn Jerzego Ż. przerwał milczenie. Padły ostre słowa: Przekręt
Reporterzy programu „Uwaga!” dotarli do rodziny Jerzego Ż., emerytowanego ślusarza, który miał sprzedać swoje mieszkanie Karolowi Nawrockiemu. „Dla mnie to jest normalne wyłudzenie mieszkania, przekręt, wykorzystanie sytuacji starszego...
KrajOpinie i komentarzePolityka
-
Ważne słowa przed konklawe. „Jest on skałą, na której zbudowany jest Kościół”
– Jesteśmy tutaj, aby wzywać pomocy Ducha Świętego, błagać o Jego światło i moc, aby został wybrany papież, którego Kościół i ludzkość tak potrzebują, znajdując się na tym trudnym i złożonym zakręcie historii – mówił kard. Giovanni...
ReligiaŚwiat
-
Dom, mieszkanie i siedlisko warte miliony. Oto majątek Szymona Hołowni
Przyjrzeliśmy się oświadczeniu majątkowemu Szymona Hołowni. Co prawda lider Polski 2050 nie opublikował jeszcze najnowszego zeznania za ubiegły rok, niemniej dokument podsumowujący pierwszy rok kadencji ukazuje stan posiadania kandydata...
KrajOpinie i komentarzePolitykaŚwiat
-
Zdjęcia maturalnego arkusza po kilku minutach były już w sieci. CKE komentuje
W środę 7 maja polscy maturzyści zdawali egzaminy z angielskiego. Arkusze znów były dostępne w sieci już po kilku minutach.
Kraj
-
Donald Tusk się nie hamował. „Nieźle zorganizowana patodeweloperka”
„PiS okazał się naprawdę nieźle zorganizowaną patodeweloperką” – napisał Donald Tusk. Premier odniósł się do afery, w której centrum jest sprawa mieszkania Karola Nawrockiego.
Opinie i komentarzeKrajWybory prezydenckie
-
Awantura w Sejmie. Czarnek oskarża: Macie krew na rękach
„Macie krew na rękach” – grzmiał z sejmowej mównicy Przemysław Czarnek z PiS, komentując wystąpienie posłanki Magdaleny Małgorzaty Kołodziejczyk z PO. Posłanka, nawiązując do afery mieszkaniowej Karola Nawrockiego, wystąpiła z wnioskiem...
KrajPolitykaOpinie i komentarze